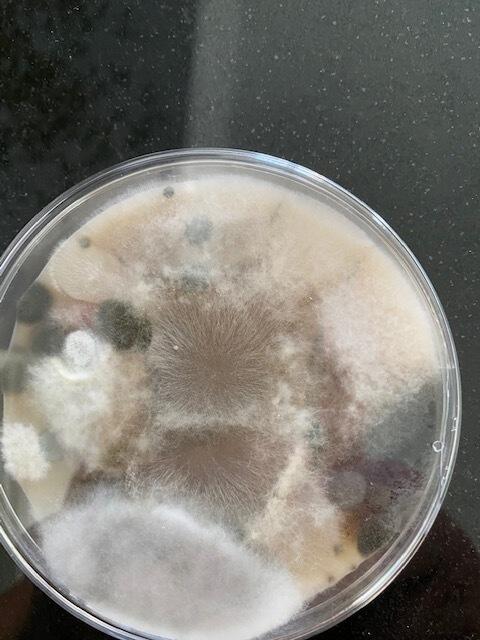

Langtidseffekter og risikogrupper
Mens kortvarig eksponering for skimmelsvamp kan forårsage midlertidige symptomer, er det de langvarige effekter, der er særligt bekymrende. Langvarig eksponering kan føre til mere alvorlige respiratoriske tilstande og forværre kroniske sundhedstilstande som astma og allergi.
Mistænker du skimmelsvamp i din bolig, men kan du ikke se skimmelsvamp nogen steder? Prøv vores lufttest - Danmarks billigste.
Risikogrupperne, som er særligt udsatte for skimmelsvamps negative effekter, omfatter:
Børn: Deres immunsystemer er stadig under udvikling, og de er mere sårbare over for luftvejsproblemer.
Ældre: Ældre personer kan have svækkede immunsystemer og eksisterende sundhedstilstande, der kan forværres af skimmelsvamp.
Personer med svækket immunforsvar: Dette inkluderer personer med autoimmune sygdomme, dem, der gennemgår kemoterapi, og personer med HIV/AIDS.
Det er klart, at skimmelsvamp ikke er et problem, der bør tages let. Det er vigtigt at være opmærksom på miljøet omkring os og træffe skridt for at reducere fugt og forbedre ventilation, især i boliger og på arbejdspladser. Hvis du eller nogen du kender oplever symptomer, der kan være relateret til skimmelsvamp, er det afgørende at søge lægehjælp og få undersøgt dit hjem for skimmelsvamp. Ved at være proaktive kan vi beskytte vores helbred og sikre, at vores omgivelser er sunde og sikre.
Læs mere om hvordan skimmelsvamp opstår.
Immunologiske reaktioner på skimmelsvamp
Mens vi lige før har berørt almindelige symptomer og risikogrupper i forbindelse med skimmelsvamp, er det også vigtigt at forstå de underliggende immunologiske reaktioner, som skimmelsvamp kan udløse i kroppen. Vores immunsystem spiller en kritisk rolle i, hvordan vi reagerer på skimmelsvamp, og dette varierer fra person til person.
Psykologiske konsekvenser af skimmelsvampseksponering
Et ofte overset aspekt ved langvarig eksponering for skimmelsvamp er de psykologiske konsekvenser. Personer, der lever eller arbejder i miljøer med høj skimmelsvamp, kan opleve:
Stress og angst: Bekymring for helbredseffekter kan skabe betydelig stress og angst, især hos dem, der allerede lider af skimmelsvampsrelaterede symptomer.
Søvnforstyrrelser: Skimmelsvamp kan forstyrre søvnkvaliteten, hvilket kan føre til yderligere sundhedsmæssige problemer.
Skimmelsvamp og kroniske sygdomme
Forskning har også indikeret en forbindelse mellem skimmelsvamp og visse kroniske sygdomme:
Astma og kronisk obstruktiv lungesygdom (KOL): Langvarig eksponering for skimmelsvamp kan være en medvirkende faktor i udviklingen af astma eller forværre symptomer hos personer med KOL.
Autoimmune sygdomme: Nogle studier har foreslået, at skimmelsvamp kan spille en rolle i udviklingen af visse autoimmune sygdomme, skønt yderligere forskning er nødvendig for at bekræfte denne forbindelse.
Det er vigtigt at tage skimmelsvamp alvorligt og træffe skridt for at bekæmpe det. Husk på følgende:
Regelmæssig inspektion: Vær proaktiv i at inspicere dit hjem for tegn på fugt og skimmelsvamp.
Professionel hjælp: Hvis du opdager skimmelsvamp, overvej at få professionel hjælp til at fjerne det sikkert.
Sundhedsundersøgelse: Hvis du oplever vedvarende symptomer, som du mistænker kan være relateret til skimmelsvamp, bør du konsultere en læge.
Ved at uddanne os selv om de sundhedsmæssige effekter af skimmelsvamp og træffe forebyggende foranstaltninger, kan vi beskytte vores helbred og forbedre vores livskvalitet betydeligt. Husk, dit hjem skal være et sikkert og sundt sted for dig og din familie.
Læs mere om skimmelsvamp test.